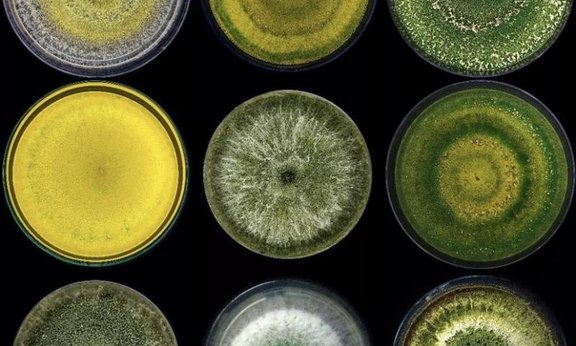

Mikrobielle Interaktionen
Molekulare Mykologie & Mykoparasitismus
Arbeitsgruppenleitung: Susanne Zeilinger

Virologie der Mikroorganismen
Arbeitsgruppenleitung: Susanne Erdmann

Phytomyxid-Host Interactions
Arbeitsgruppenleitung: Sigrid Neuhauser

Pilzsystematik und Taxonomie
Arbeitsgruppenleitung: Martin Kirchmair